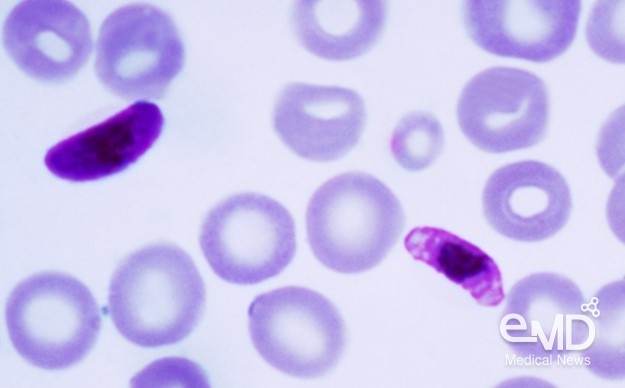

한국로슈진단㈜(대표이사 킷 탕)은 헌혈 혈액 내에 5종의
말라리아 원충을 핵산증폭검사(NAT)법으로 선별하는 검사인 코바스 말라리아(cobas®
Malaria)가 최근 식품의약품안전처로부터
체외진단의료기기로 허가받았다고 26일 밝혔다. 해당 검사는 헌혈 혈액 내 말라리아 선별을 목적으로 한 혈액선별용 감염체
유전자 검사 시약으로서 국내 첫 허가 제품이며, 대용량 자동화 분자진단 검사 장비인 cobas 5800 system[1], cobas 6800 system[2]과 cobas 8800 system[3]에서
사용 가능하다.
코바스
말라리아는 CE인증, FDA 승인을 받은 검사로, 임상적 민감도 및 특이도 시험 결과 100%[4]의 rRNA, DNA 듀얼 타깃 PCR 설계를 적용해,
검체 내 말라리아 원충이 1개만 존재하더라도 검출 가능하도록 설계되어, 보다 효과적인 선별검사를 지원한다.[5]
말라리아
원충은 모기로부터 감염을 일으켜 급성 열성 전염병을 일으키며[6] 세계보건기구(World Health Organization, 이하 WHO)의 2022년 보고서에 따르면, 2021년
한 해 동안 84개 국가에서 약 2억
4,700만 명의 환자가 발생했으며, 이 중 95%는 아프리카에서
보고됐다.[7]
우리나라는 2017년부터 WHO로부터 말라리아 우선 퇴치
대상국으로 지정돼 있으며, OECD 국가 중에서는 한국, 멕시코, 코스타리카만이 포함되었다.
현재
국내에서는 헌혈 혈액에 대해 말라리아 면역 검사가 시행돼 왔으나, 항체 생성 이전에는 감염 여부를 확인할
수 없다는 한계로 인해 수혈 안전성을 위협하고 헌혈 제한 지역이 발생하는 문제가 있었다. 이로 인해 면역
검사에서의 교차반응이 불필요한 혈액 폐기를 야기하기도 한다.[8]
현재
국내에서는 말라리아 위험 지역 거주자 및 방문자에 대한 헌혈 1년 보류 조치를 시행하고 있으며,[9]이는 WHO가 권고하는 최소 4개월 기준[10]을
크게 상회하는 수준이다. 최근 국내
연구진에 따르면, 헌혈제한지역의 잠재적 헌혈자는 연간 약 31,208명으로
추산된다.[11]
로슈진단의 말라리아 PCR 검사가 현장에 도입되면, 헌혈
보류 기간을 합리적으로 단축해 소중한 혈액 자원을 환자들에게 공급하고, 국가적 혈액 수급난 해소에 기여할
수 있을 것으로 기대된다.
한국로슈진단
킷 탕(Kit Tang) 대표이사는 “글로벌에서 검증된 코바스 말라리아
검사를 한국에 출시하게 되어 매우 뜻깊게 생각한다. 이를 통해 의료진에게 신뢰할 수 있는 헌혈자 선별 도구를
제공함은 물론 수혈 안전성을 한층 강화해 환자들의 수혈 관련 위험을 줄이는 데 기여할 것으로 기대한다.”며, “또한 이번 출시는 한국의 말라리아 퇴치 노력에도 힘을 보탤 것으로 기대된다. 앞으로도
한국로슈진단은 대한민국 의료 현장의 신뢰할 수 있는 파트너로서 혈액 안전의 새로운 기준을 만들어가겠다.”고
덧붙였다.
[8] https://www.kjbt.org/journal/view.html?uid=852&&vmd=Full', 백종헌의원실 보도자료https://www.peoplepowerparty.kr/news/lawmaker_inspection_view/109825
[11] 헌혈자 선별
및 혈액검사 적격
기준 개선방안 마련
연구(2025.12.17
보건복지부 혈액장기정책과)
